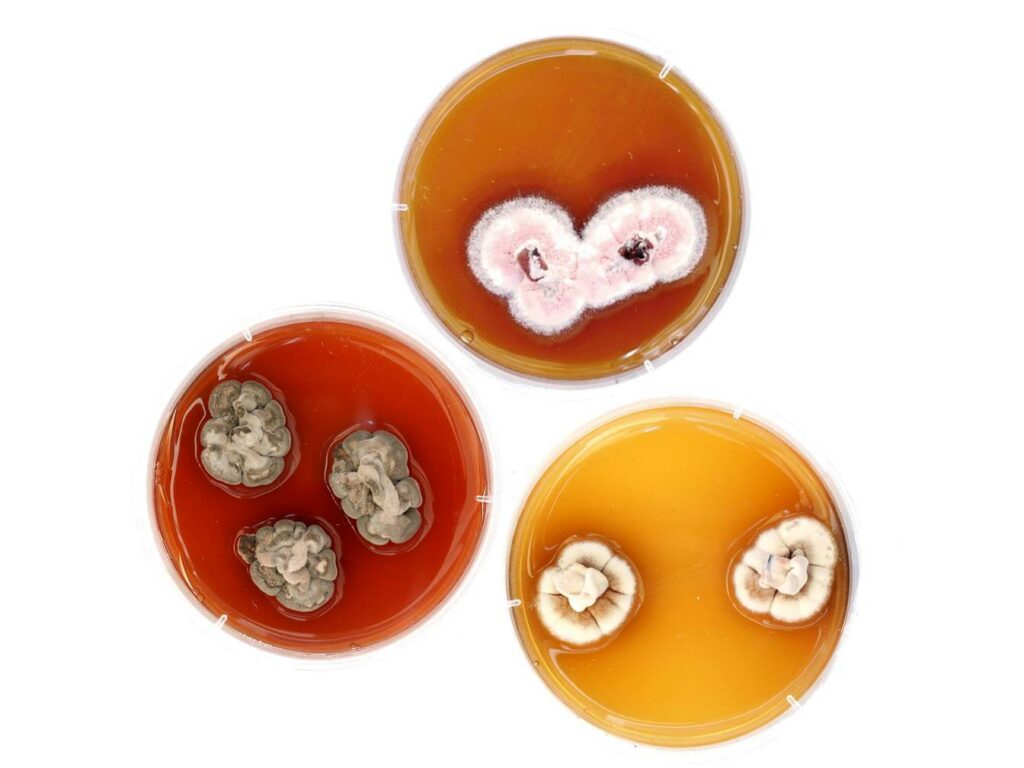

Mgr. Katarína Adamčíková, PhD.
Vedúca oddelenia
Oblasť výskumu
Oddelenie fytopatológie a mykológie sa zaoberá patológiou drevín v mestskej zeleni a lesných porastoch, identifikáciou hubových patogénov a hmyzích škodcov, štúdiom vzťahov hostiteľ – patogén aj biológiou patogénov. Výskumný tím sa venuje aj taxonómii a diverzite húb, metódam v ochrane drevín a vplyvu entomopatogénnych húb na populácie hmyzích škodcov. Výskum zahŕňa aj štúdium vplyvu klimatických a stanovištných podmienok na výskyt a šírenie hubových ochorení a hmyzích škodcov drevín.
Okrem základného výskumu sa zameriavame aj na aplikovaný výskum (expertízne posudky ohľadom zdravotného stavu a stability drevín).
Výskum zahŕňa:
- sledovanie a monitorovanie šírenia húb a/alebo ochorení, hostiteľského spektra, intenzity a rozsahu ochorenia
- izoláciu a identifikáciu hubových patogénov drevín (karanténne, invázne, introdukované druhy)
- taxonómiu, diverzitu a morfologickú variabilitu húb
- vzájomné vzťahy medzi nepohlavným a pohlavným štádiom húb
- popis a charakterizáciu hubových kultúr (virulencia, vegetatívna kompatibilita, mykovírusy, reprodukčný systém)
- ochranné opatrenia: biologické (mykovírusy, entomopatogénne huby, antagonizmus), chemické (injektáž), rezistencia (identifikácia odolných jedincov, náchylnosť drevín)
- vplyv klimatických a stanovištných podmienok na výskyt a šírenie chorôb
- štúdium entomopatogénnych húb infikujúcich hmyzích škodcov drevín, identifikáciu a prevalenciu týchto húb v populáciách hostiteľa, laboratórne testy virulencie
- biológiu a ekológiu inváznych druhov hmyzu troficky viazaných na dreviny
- populačné štúdie ako populačná štruktúra a diverzita, spôsob šírenia, tok génov a spôsob reprodukcie a geografického šírenia hubových patogénov
Ciele
- analyzovať príčiny odumierania stromov a vzájomné vzťahy medzi hostiteľom a škodlivými činiteľmi
- študovať vplyv abiotických a biotických faktorov na okrasné dreviny v mestskom prostredí
- študovať biológiu a reguláciu rastlinných patogénov pomocou tradičných, biotechnologických a ekologických metód
- identifikovať bioklimatické a geografické faktory ovplyvňujúce areál rozšírenia hubových patogénov v súvislosti s klimatickými zmenami
- študovať úlohu entomopatogénnych húb v regulácii populácií hmyzích škodcov
- vývoj nových metód začlenenia entomopatogénnych húb do integrovaného systému ochrany drevín

Služby
Nedeštruktívna metóda AKUSTICKEJ TOMOGRAFIE pri hodnotení stability drevín vo verejnej zeleni
Objektívne stanovenie stability drevín nie je možné iba na základe vizuálneho posúdenia (skryté dutiny, začínajúca hniloba).
Pre zvýšenie objektivity posúdenia či niektorá drevina neohrozuje zdravie, bezpečnosť, príp. majetok odporúčame prístrojové hodnotenie stability.
Akustická tomografia
- patrí medzi profilové metódy, pri ktorých sa hodnotí priečny rez kmeňa
- tomograf Fakopp 3D nedeštruktívnou metódou deteguje veľkosť a polohu hniloby a dutín vo vnútri kmeňa stromu
- princíp spočíva v meraní rýchlosti šírenia zvukových vĺn (s presnosťou na mikrosekundy) medzi viacerými senzormi po obvode kmeňa hodnoteného stromu, pričom rýchlosť klesá pri výskyte hniloby alebo dutiny vo vnútri kmeňa
- výsledný tomogram predstavuje digitálny prierez vnútornej štruktúry kmeňa v hodnotenej vrstve (2D), prípadne vo viacerých vrstvách (3D)
- ArborSonic 3D základe tomogramu a parametrov výšky stromu, plochy koruny, sklonu kmeňa, maximálnej rýchlosť vetra vypočíta bezpečnostný faktor stability dreviny
- hodnotenie stability dreviny v teréne trvá iba 10-30 minút, je možné realizovať takmer celoročne

2D tomogram zdravej dreviny

2D a 3D tomogram poškodenej dreviny so zníženou stabilitou
Expertíza zahŕňa
- vizuálne posúdenie zdravotného stavu
- prístrojové hodnotenie stability akustickým tomografom Fakopp3D (Fakopp Bt., HU)
- vypracovanie expertízneho posudku stability hodnotených drevín s príslušnou fotodokumentáciou
- návrh následných opatrení na udržanie, príp. zvýšenie stability drevín
Referencie
- Mestské a obecné úrady (Bratislava, Žilina, Komárno, Trnava, Pezinok, Martin, Nitra, Zvolen, Oponice, Dubová, Marcelová…)
Ohodnotenie a cenová ponuka
V prípade záujmu o hodnotenie stability drevín a pre zaslanie cenovej ponuky nás kontaktujte:
- @: katarina.adamcikova@ife.sk
- T: +421 908 902 539
Na stiahnutie
- Leták
- Objednávka
Hodnotenie stability koreňového systému drevín metódou DynaRoot
Pre komplexné zhodnotenie stability a bezpečnosti celej dreviny je nevyhnutné posúdiť stav koruny a kmeňa (metódami vizuálneho hodnotenia, príp. akustickej tomografie kmeňa) ako aj stav koreňového systému. Častým problémom u drevín môže byť nebezpečenstvo vývratu celej dreviny aj s koreňmi v dôsledku poškodenia koreňového systému.
Stabilita koreňového systému metódou DynaRoot
- hodnotí odolnosť celej dreviny voči vývratu
- využíva prirodzenú silu vetra v reálnych podmienkach na hodnotenie dynamickej stability koreňov
- patrí medzi komplexné metódy, pri ktorých sa hodnotí stabilita dreviny ako celku
- systém pozostáva z presného anemometra na zaznamenávanie smeru a rýchlosti vetra vo výške koruny (stožiar s výškou 10 m) a vysokocitlivých inklinometrov na zaznamenávanie náklonu bázy kmeňa (s presnosťou 0,001°)
- pokročilými štatistickými analýzami získaných dát je softvérom DynaTree (Fakopp Bt., HU) vypočítaný bezpečnostný faktor, ktorý stanovuje odolnosť dreviny voči vývratu
- hodnotenie stability koreňového systému v teréne trvá minimálne 2-4 hodiny, za podmienky výskytu nárazového vetra (min. 25 km/h) na lokalite v čase hodnotenia
- hodnotenie ihličnatých drevín je možné celoročne, listnaté dreviny sa odporúča hodnotiť v čase olistenia

Diagram, kritický nápor vetra, korelačný koeficient a výsledný bezpečnostný faktor (BF) stability
Hodnoty bezpečnostného faktora (BF)
- BF > 1.5 = nízke riziko
- BF 1.0 – 1.5 = stredné riziko
- BF < 1.0 = vysoké riziko
Expertíza zahŕňa
- vizuálne posúdenie zdravotného stavu
- prístrojové hodnotenie stability koreňového systému metódou DynaRoot (Fakopp Bt., HU)
- vypracovanie expertízneho posudku stability hodnotených drevín s príslušnou fotodokumentáciou
- návrh následných opatrení
Cenová ponuka
V prípade záujmu o hodnotenie stability koreňového systému drevín a pre zaslanie cenovej ponuky nás kontaktujte:
- @: katarina.adamcikova@ife.sk
- T: +421 908 902 539
Na stiahnutie
- Leták
- Objednávka
Mapová zostava z riešenia projektu VEGA 2/0062/18
Mapová zostava lokalít s výskytom huby Hymenoscyphus fraxineus na jaseňoch na Slovensku.
Detailnejšie informácie o objektoch na mape je možné získať pomocou funkcií „Nástroj Dáta objektu“, prípadne „Nástroj Geopriestorové umiestnenie“ v rámci nástrojovej lišty „Mierka“ programu Adobe Acrobat Reader©. Program je možné stiahnuť na tomto odkaze.
Na stiahnutie